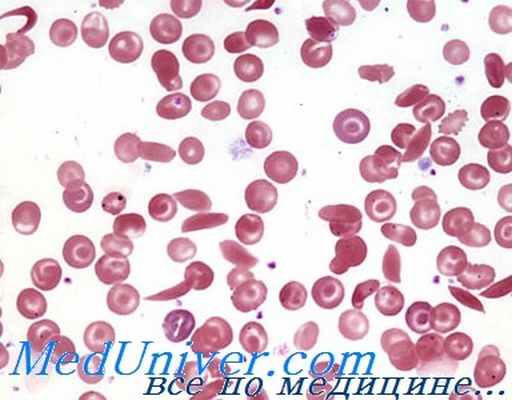
серповидноклеточная анемия

Генетика серповидноклеточной анемии. Наследование
Добавил пользователь Алексей Ф. Обновлено: 06.01.2026
Серповидная клетка является наследственным расстройством крови, при котором эритроциты (эритроциты), которые переносят кислород вокруг тела, развиваются аномально.
При серповидноклеточной анемии форма клетки деформируется, они становятся жесткими и имеют форму полумесяца (или серпа). Серповидные эритроциты легко разламываются, вызывая анемия .Серповидные клетки крови не могут нормально функционировать и преждевременно погибают (они живут всего 10-20 дней вместо обычных 120 дней).
Серповидные клетки содержат дефектный гемоглобин. Люди с серповидно-клеточными состояниями делают другую форму гемоглобина. А называемый гемоглобин S (S обозначает серп. Эти аномальные клетки не могут передвигаться так же легко, как клетки нормальной формы, и могут блокировать кровеносные сосуды, что приводит к повреждению тканей и органов и эпизодам тяжелой боль. (Эти клетки слипаются и прилипают к стенкам кровеносных сосудов, блокируя кровоток).
Эти эпизодические боли известны как кризис серповидноклеток или вазо-окклюзионный кризис. Человек может не знать, что вызвало боль, но инфекция и обезвоживание являются обычными причинами. Они могут длиться от нескольких минут до нескольких месяцев, но в среднем длятся от пяти до семи дней.
Красные кровяные тельца содержат гемоглобин, белок, переносящий кислород в кровь. Нормальные эритроциты мягкие, круглые и гибкие (могут протискиваться через крошечные кровеносные сосуды), что позволяет им перемещаться по мелким кровеносным сосудам, доставляя кислород ко всем частям тела. Обычно красные кровяные тельца живут около 120 дней, прежде чем новые. замените их.
гемоглобин является основным веществом красных кровяных телец. Это помогает эритроцитам переносить кислород из воздуха в наших легких во все части тела. Нормальные эритроциты содержат гемоглобин A. Гемоглобин S и гемоглобин C являются аномальными типами гемоглобина.
Узнать больше:
Причины анемии в серповидноклеточной анемии
Генетика анемии анемии
Серповидная клетка вызвана генетической мутацией (аномальным) изменением гена, которое влияет на нормальное развитие гемоглобина.
Генетическая мутация - это постоянное изменение нормального паттерна генетической информации во всех живых клетках. Это приводит к тому, что один или несколько процессов в организме не работают должным образом.
Ген серповидной клетки наследуется аутосомно-рецессивным образцом (передается между членами семьи). Чтобы получить серповидноклеточную анемию, вы должны наследовать дефектный ген от обоих родителей. Это означает, что ребенок не наследует болезнь, если оба родителя не сдадут дефектную копию этого гена. Люди, которые наследуют одну хорошую копию гена и одну мутированную копию, являются носителями. Они клинически нормальные, но все равно могут передавать дефектный ген своим детям.
Шансы на анемию серповидно-клеточной анемии:
шанс каждого из четырех, что ваш ребенок получит пару нормальных генов гемоглобина
один шанс на два, что ваш ребенок получит один нормальный ген и один мутированный ген и будет носителем гена клетки серпа
шанс каждого из четырех может получить пару мутированных генов и иметь серповидноклеточную анемию
Что такое червоточина анемии?
Люди, которые унаследовали один ген серповидноклеточной системы и один нормальный ген, имеют серповидно-клеточную характеристику (SCT). Серповидно-клеточная анемия не считается болезненным состоянием, поскольку она имеет редкие или легкие осложнения.
Вполне вероятно, что кровь будет содержать серповидные клетки, но они будут способны вырабатывать нормальный гемоглобин и обычно не испытывают симптомов. Однако они будут носителями серповидноклеточной анемии и могут передать аномальный ген своим детям.
Как наследуется свойство Sickle Cell Trait:
Если оба родителя имеют SCT, существует вероятность 50% (или 1 в 2), что у любого из них также будет SCT, если ребенок наследует ген клетки серпа от одного из родителей. У таких детей не будет симптомов SCD, но они могут передать SCT своим детям.
Если у обоих родителей есть SCT, существует 25% (или 1 из 4) шанс, что у любого из их детей будет SCD. Существует тот же 25% (или 1 из 4) шанс, что у ребенка не будет SCD или SCT.
Диагноз:
SCT диагностирован с простым анализом крови. Люди, которым грозит заражение ПКТЗ, могут поговорить с врачом или клиник о проведении этого теста.
Проводится нормальный анализ крови, который включает:
нормальная морфология красных клеток,
Выживание эритроцитов путем маркировки хромом.
Симптомы анемии
Болезнь серповидноклеточной болезни препятствует проникновению кислорода в селезенку, печень, почки, легкие, сердце или другие органы, наносящие много урона. Без кислорода клетки, которые составляют эти органы, умирают.
Серповидная клетка может вызывать широкий спектр симптомов, хотя не у всех с этим заболеванием проявляются все симптомы. Некоторые признаки серповидноклеточной анемии, такие как утомляемость, анемия, болевые кризы и инфаркты костей, могут возникнуть в любом возрасте. Многие особенности обычно встречаются в определенных возрастных группах.
Признаки и симптомы серповидноклеточной анемии часто не появляются до тех пор, пока младенец не достигнет 4 месяцев и может включать:
малокровие
Серповидная клетка вызывает хроническую форму анемии, которая может привести к усталости. Серповидные эритроциты подвержены разрушению (гемолизу), что приводит к сокращению продолжительности жизни эритроцитов (нормальная продолжительность жизни эритроцитов составляет 120 дней). Это приводит к длительной нехватке эритроцитов (анемия).
Без достаточного количества красных кровяных клеток в кровообращении организм не может получить кислород, необходимый ему для возбуждения. Вот почему анемия вызывает усталость.
Симптомы анемии включают:
усталость - сильная усталость и общее отсутствие энергии
сердцебиение (нерегулярное сердцебиение)
Эпизоды боли
Периодические эпизоды боли, называемые кризисами, являются основным симптомом серповидной клетки. Болевые кризисы у лиц с серповидноклеточной анемией - это эпизодические болезненные эпизоды, которые являются результатом недостаточного кровоснабжения тканей организма. Нарушение кровообращения вызвано блокировкой различных кровеносных сосудов от серповидных клеток крови.
Серповидные эритроциты замедляют или полностью препятствуют нормальному течению крови через ткани. Это приводит к мучительной боли, часто требующей госпитализации и лечения для облегчения.
Боль обычно пульсирующая и может меняться от одной области тела к другой. Часто поражаются кости. Боль в животе с нежностью является обычным явлением и может имитировать аппендицит. Лихорадка часто сопровождается болевыми кризами.
Человек может не знать, что вызвало боль, но одна или несколько из следующих ситуаций могут вызвать болезненный серповидный криз:
Употребление наркотиков и алкоголя
Беременность и стресс
Бактериальная инфекция
Инфекция легких (пневмония) чрезвычайно распространена у детей с серповидно-клеточной анемией, а также является самой распространенной причиной госпитализации.
Дети с серповидно-клеточной анемией также подвержены риску инфицирования мозга и спинномозговой жидкости (менингит). Бактерии, которые являются частыми причинами этой инфекции, включают бактерии Pneumococcus и Haemophilus.
Дактилиты и артрит
Отек и воспаление рук и / или ног часто являются ранним признаком малокровия клеток серпа. Набухание включает целые пальцы и / или пальцы ног и называется Дактилитом
Распухшие руки и ноги могут быть первыми признаками малокровия клеток серпа у младенцев. Опухоль вызвана серповидными красными кровяными клетками, блокирующими кровоток из их рук и ног.
Дактилиты могут сопровождаться совместным воспалением (артритом) с болью, отеком, болезненностью и ограниченным диапазоном движения. Иногда затрагиваются не только суставы рук или ног, но и колено или локоть.
Селезенка селезенки и перегрузка печени
Печень и селезенка - это органы, которые очень активно удаляют серповидные эритроциты из кровообращения людей с серповидно-клеточной анемией. Этот процесс может внезапно ускориться. Внезапное скопление крови в селезенке называется секвестрацией селезенки. У этих пациентов может развиться шок и потерять сознание. Секвестрация селезенки может вызвать очень тяжелую анемию и даже привести к смерти.
Лунг и сердечная травма
Помимо инфекции легких (пневмония), легкие детей с серповидноклеточной анемией также могут быть ранены из-за недостаточного кровообращения, которое вызывает области смерти тканей. Это повреждение легких может быть трудно отличить от пневмонии и известно как синдром острой грудной клетки. Эти локализованные области повреждения тканей легких называются легочными инфарктами
Сердце часто увеличивается у детей с серповидноклеточной анемией. Часто наблюдаются учащенное сердцебиение и шумы. Сердечная мышца также может быть повреждена инфарктами и отложением железа в мышце, когда оно вытекает из разорванных красных кровяных телец. Со временем сердечная мышца ослабевает, и сердце все хуже перекачивает кровь.
Язвы ног
Ноги пациентов с серповидноклеточной анемией восприимчивы к разрушению кожи и изъязвлению. Язвы язвы чаще всего встречаются у взрослых и обычно образуют над лодыжками и боками нижних ног. Язвы могут стать серьезными, даже окружая ногу, и подвержены инфекции.
Асептический некроз и костные инфаркты
Асептический некроз, или локальная смерть кости, является результатом недостаточного снабжения кости кислородом. Его также называют остеонекрозом. Хотя может быть поражена практически любая кость, наиболее распространенными являются кости бедер, ног и рук. В результате могут быть необратимо повреждены или деформированы бедра, плечи или колени.
Признаки асептического некроза включают:
Повреждение глаз
Некоторые люди с серповидно-клеточной анемией испытывают проблемы со зрением. Крошечные кровеносные сосуды, кровоснабжающие глаза, могут забиваться серповидными клетками. Это может повредить сетчатку - часть глаза, обрабатывающую зрительные изображения. Кровотечение также может происходить внутри глаза (кровоизлияние в сетчатку), что может привести к отслоению сетчатки. Отслоение сетчатки может привести к слепоте
Дополнительные симптомы:
Остеопороз, вызывающий ослабление костей
Повреждение почек и инфекция
Повреждение нервной системы: нарушение кровообращения в головном мозге может вызвать инсульт, судороги и приступы.
Приапизм: ненормально стойкая эрекция полового члена при отсутствии полового влечения может возникнуть у людей с серповидно-клеточной анемией. Приапизм может привести к импотенции и повреждению пораженных тканей.
Тест и диагностика
Серповидноклеточные тесты используются для определения наличия гемоглобина S, для оценки состояния и количества эритроцитов (эритроцитов) человека, а также уровня гемоглобина и / или для определения наличия у человека одной или нескольких измененных копий гена гемоглобина. . Присутствие других аномальных вариантов гемоглобина может быть замечено, но для определения конкретного типа потребуется дополнительное тестирование.
Пренатальное тестирование
Врачи могут диагностировать серповидно-клеточную болезнь до рождения ребенка (пренатально). Пары, которые рискуют передать эту болезнь своим детям, могут поговорить со своим врачом о предродовом испытании, которое включает:
Амниоцентез: жидкость, окружающая ребенка в утробе матери (амниотическая жидкость), извлекается и отбирается для поиска гена серповидных клеток. Тестирование до родов можно проводить уже на 8–10 неделе беременности.
Хроническая выборка ворсинок
Детский скрининг
Сердечная болезнь сердца может быть диагностирована при рождении. Вскоре после рождения образец крови взят из пятки младенца и отправляется в лабораторию, где он подвергается скринингу на наличие гемоглобина клеток серпа (гемоглобин S).
Взрослый скрининг
Если один из членов пары имеет серповидную клеточную болезнь или серповидную клеточную признаку, другой член должен быть протестирован, прежде чем забеременеть. Этот тест требует образца крови, который скринирован на присутствие гемоглобина S, гемоглобина C или бета-талассемии.
Тесты, обычно проводимые для диагностики и наблюдения за пациентами с серповидноклеточной анемией, включают:
Насыщение кислородом крови
Полный анализ крови (CBC)
Оценка гемоглобинопатии (Hb): Существует несколько методов оценки типа и относительных количеств различных нормальных и аномальных типов гемоглобина. Эти методы обычно разделяют различные типы гемоглобина, которые присутствуют, чтобы их можно было идентифицировать и количественно определить. Они включают:
Электрофорез гемоглобина, традиционно используемый в качестве метода идентификации присутствия различных гемоглобинов
Фракционирование гемоглобина с помощью ВЭЖХ, наиболее часто используемый метод скрининга вариантов гемоглобина, включая Hb S
Анализ ДНК: этот тест используется для исследования изменений и мутаций в генах, производящих компоненты гемоглобина. Его можно выполнить, чтобы определить, есть ли у человека одна или две копии мутации Hb S или две разные мутации в генах гемоглобина (например, Hb S и Hb C).
Мазок крови (также называемый периферическим мазком и ручным дифференциалом): количество и тип эритроцитов оцениваются, чтобы убедиться, что они нормальные. На кровяном мазке видны серповидные эритроциты.
Исследования железа: они могут включать: железо, ферритин, UIBC, TIBC и насыщение трансферрина. Эти тесты измеряют различные аспекты хранения и использования железа в организме. Им приказывают помочь определить, есть ли у кого-то железодефицитная анемия или избыточное количество железа (перегрузка железом).
Лечение анемии матки
Цель лечения - управлять симптомами и контролировать их, а также ограничивать количество кризов. Людям с серповидно-клеточной анемией необходимо постоянное лечение, даже если у них нет криза. Лучше всего получать помощь в медицинских учреждениях, которые заботятся о многих пациентах с серповидно-клеточной анемией. Людям с этим заболеванием следует принимать добавки с фолиевой кислотой. Фолиевая кислота помогает создавать новые эритроциты.
Лечение кризиса серповидной клетки включает:
Переливание крови (также может регулярно назначаться для предотвращения инсульта)
Боль лекарств
Лекарства, облегчающие боль
Гидроксимочевина (Droxia, hydrea)
Много жидкостей
Дополнительный кислород: Дыхание дополнительного кислорода через дыхательную маску добавляет кислород в вашу кровь и облегчает вам дыхание. Это может быть полезно, если у вас синдром острой грудной клетки или кризис клеток серпа.
Лечение детей:
Регулярные прививки детям.
Ежедневные антибиотики с 2 месяцев до 5 лет для предотвращения опасных для жизни инфекций. Эта практика прекращается в возрасте 5 лет, потому что у детей старшего возраста не так много тяжелых инфекций.
Мультивитаминные добавки с железом в младенчестве.
Добавки фолиевой кислоты
Протеиновые добавки, если наблюдается отставание в наборе веса.
Начиная с 2 лет, вашему ребенку следует часто проходить скрининг с помощью транскраниального УЗИ. Этот тест измеряет кровоток в артериях головы и шеи. Если результаты анализов показывают высокую вероятность инсульта, вашему ребенку могут сделать переливание крови, чтобы снизить риск.
прогноз
Новые и агрессивные методы лечения серповидноклеточной анемии продлевают жизнь и улучшают ее качество. Еще в 1973 году средняя продолжительность жизни людей с серповидно-клеточной анемией составляла всего 14 лет. В настоящее время продолжительность жизни таких пациентов может достигать 50 лет и более.
Ожидаемая продолжительность жизни лиц с серповидноклеточной анемией снижается. Некоторые пациенты, однако, могут оставаться без симптомов в течение многих лет, в то время как другие не переживают младенчества или раннего детства. Тем не менее, с оптимальным управлением, пациенты теперь могут выжить за четвертое десятилетие.
Большинство пациентов страдают от прерывистых болевых синдромов, усталости, бактериальных инфекций и прогрессирующей ткани и повреждения органов. Нарушение роста и развития является конечным результатом физической и эмоциональной травмы, которую испытывают дети с серповидноклеточной анемией. Женщины с серповидной клеткой живут дольше, чем мужчины-мужчины. ,
Имя автора
Доктор Пуджа Чаудхари
Дата публикации
: 02-Jun-2016
Доктор Пуджа Чаудхари - известный блогер о здоровье. Она пишет для некоторых известных медицинских сайтов в Индии и США.
Решение задач по генетике на наследование серповидноклеточной анемии и гемофилии
Задача 189.
У супругов с III группой крови и легкой формой серповидноклеточной анемии 1 родился ребенок с I группой крови и тяжелой формой серповидноклеточной анемии. Сколько может быть среди детей этих супругов разных: 1 - фенотипов; 2 - генотипов? Какова вероятность (в частях) рождения в этой семье: 3 - здорового ребенка; 4 - ребенка, фенотипически похожего на родителей; 5 - здорового ребенка с I группой крови?
Решение:
HbА - ген нормального гемоглобина (нормальный эритроцит);
HbS - ген серповидноклеточной анеми;
HbSHbS - особь погибает от анемии (сильная анемия);
HbAHbS - особи жизнеспособны и устойчивы к малярии (лёгкая форма серповидноклеточной анемии);
HbАHbА - особи здоровы.
За наследование групп крови у человека отвечают три гена: I 0 - ген I-й группы крови; I A - ген II-й группы крови; I B - ген III-й группы крови. Наличие двух каких-либо аллелей в генотипе человека отвечает за группу крови, причем аллель I0 является рецессивной по отношению к I A и I B . Возможные генотипы групп крови у человека:
I 0 I 0 - I-я группа крови;
I A I 0 - II-я группа крови;
I A I A - II-я группа крови;
I B I 0 - III-я группа крови;
I B I B - III-я группа крови;
I A I B - IV-я группа крови.
Так как у супругов с III группой крови и легкой формой серповидноклеточной анемии родился ребенок с I группой крови и тяжелой формой серповидноклеточной анемии, то они оба гетерозиготы и по группе крови и по гемоглобину, поэтому их генотип имеет вид: IBI0HbSHbS.
Схема скрещивания
Р: I B I 0 HbSHbS х I B I 0 HbSHbS
Г: I B HbA; I B HbS I B HbA; I B HbS
I 0 HbA; I 0 HbS I 0 HbA; I 0 HbS
F1:
1I B I B HbAHbA - 6,25%; 2I B I B HbAHbS - 12,5%; 2I B I 0 HbAHbA - 12,5%; 4I B I 0 HbAHbS - 25%; 2I B I 0 HbSHbS - 12,5%; 1I B I B HbSHbS - 6,25%; 1I 0 I 0 HbAHbA - 6,25%; 2I 0 I 0 HbAHbS - 12,5%; 1I 0 I 0 HbSHbS - 6,25%/.
Наблюдается 9 типов генотипа. Расщепление по генотипу - (1:2:2:4:2:1:1:2:1).
Фенотип:
I B I B HbAHbA - III группа крови, нормальный гемоглобин (нормальный эритроцит) - 6,25%;
I B I B HbAHbS - III группа крови, лёгкая форма серповидноклеточной анемии - 12,5%;
I B I 0 HbAHbA - III группа крови, нормальный гемоглобин (нормальный эритроцит) - 12,5%;
I B I 0 HbAHbS - III группа крови, лёгкая форма серповидноклеточной анемии - 25%;
I B I 0 HbSHbS - III группа крови, тяжёлая форма серповидноклеточной анемии (особь погибает от анемии) - 12,5%;
I B I B HbSHbS - III группа крови, тяжёлая форма серповидноклеточной анемии (особь погибает от анемии) - 6,25%;
I 0 I 0 HbAHbA - I группа крови, нормальный гемоглобин (нормальный эритроцит) - 6,25%;
2I 0 I 0 HbAHbS - I группа крови, лёгкая форма серповидноклеточной анемии - 12,5%;
I 0 I 0 HbSHbS - I группа крови, тяжёлая форма серповидноклеточной анемии (особь погибает от анемии) - 6,25%/.
Наблюдаемый фенотип:
III группа крови, нормальный гемоглобин (нормальный эритроцит) -18,75%;
III группа крови, лёгкая форма серповидноклеточной анемии - 37,5%;
III группа крови, тяжёлая форма серповидноклеточной анемии (особь погибает от анемии) - 18,75%;
I группа крови, нормальный гемоглобин (нормальный эритроцит) - 6,25%;
I группа крови, лёгкая форма серповидноклеточной анемии - 12,5%;
I группа крови, тяжёлая форма серповидноклеточной анемии (особь погибает от анемии) - 6,25%.
Наблюдается 6 типов фенотипа. Расщепление по фенотипу - 6:3:3:2:1:1.
Выводы:
1) разных фенотипов - 6;
2) разных генотипов - 9;
3) вероятность (в частях) рождения в этой семье здорового ребенка - 4;
4) вероятность (в частях) рождения в этой семье ребенка фенотипически похожего на родителей - 6;
5) вероятность (в частях) рождения в этой семье здорового ребенка с I группой крови - 1.
Несвёртываемость крови - гемофилия
Задача 190.
Рецессивный ген гемофилии (несвертываемость крови) находится в Х-хромосоме. Отец девушки здоров, мать здорова, но ее отец был болен гемофилией. Девушка выходит замуж за здорового юношу. Что можно сказать об их будущих детях и внуках?
Решение:
Х Н - ген нормальной свертываемости крови;
Х h - ген нормальной свертываемости крови;
Х Н Y - здоровый мужчина;
Х h Y - мужчина-гемофилик;
Х Н Х Н - здоровая женщина;
Х Н Х h - здоровая женщина, носительница гена гемофилии;
Х h Х h - женщина-гемофилик.
Так как у матери девушки отец страдал гемофилией, то она является носительницей гена гемофилии, но внешне является здоровой, то ее генотип - Х Н Хh. Генотип здорового отца - Х Н Y.
1. Девушка является носительницей гена гемофилии
Схема скрещивания (1)
Р: Х Н Х h х Х Н Y
Г: Х Н ; Х h Х Н ; Y
F1: X H X H - 25%; X H X h - 25%; Х Н Y - 25%; Х h Y - 25%.
Наблюдается 4 типа генотипа. Расщепление по генотипу - 1:1:1:1.
Фенотип:
X H X H - девочка здорова - 25%;
X H X h - девочка здорова, носительница - 25%;
Х Н Y- мальчик здоров - 25%;
Х h Y - мальчик-гемофилик - 25%.
Внешнее проявление признака:
здоровый организм - 75%;
гемофилик - 25%.
Наблюдается 2 типа фенотипа. Расщепление по фенотипу - 3:1.
Выводы:
1) в данном браке все девочки рождаются здоровыми, но вероятность рождения девочек, которые являются здоровыми носительницами этого гена, составляет 50% среди всех девочек и 25% - среди общего числа родившихся детей%.
2. Девушка здорова и не является носительницей гена гемофилии
Если девушка здорова и не является носительницей гена гемофилии, то выйдя замуж за здорового мужчину будет рожать здоровых девочек и мальчиков и ее внуки тоже будут здоровы. Что можно подтвердить схемой скрещивания:
Схема скрещивания (2)
Р: Х Н Х Н х Х Н Y
Г: Х Н Х Н ; Y
F1: X H X H - 50%; Х Н Y - 25%.
Наблюдается 2 типа генотипа. Расщепление по генотипу - 1:1.
Фенотип:
X H X H - девочка здорова - 50%;
Х Н Y - иальчик здоров - 50%.
Наблюдается 1 тип фенотипа. Расщепления по фенотипу - нет.
Выводы:
1) в данном браке все девочки и мальчики рождаются здоровыми.
3. Вероятность появления потомства у детей
Если девушка здорова, но является носительницей гена гемофилии, то выйдя замуж за здорового мужчину будет рожать здоровых девочек, половина из которых являются носительницами гена гемофилии, а также половина здоровых мальчиков и половина больных мальчиков. Что можно подтвердить схемой скрещивания:
Р: Х Н Х h х Х Н Y
Г: Х Н ; Х h Х Н ; Y
F1: X H X H - 25%; X H X h - 25%; Х Н Y - 25%; Х h Y - 25%.
Наблюдается 4 типа генотипа. Расщепление по генотипу - 1:1:1:1.
Фенотип:
XHXH - девочка здорова - 25%;
XHXh - девочка здорова, носительница - 25%;
ХНY- мальчик здоров - 25%;
ХhY - мальчик-гемофилик - 25%.
Внешнее проявление признака:
здоровый организм - 75%;
гемофилик - 25%.
Наблюдается 2 типа фенотипа. Расщепление по фенотипу - 3:1.
Выводы:
1) вероятность рождения гемофиликов составляет 25%, все больные - мальчики;
2) вероятность рождения носителей гена гемофилии составляет 25%, все носители - девочки;
3) у мальчиков-гемофиликов, при браке со здоровой женщиной, будут рождаться здоровыми все дети, но все девочки будут носителями гена гемофилии;
4) у девочек-носительниц гена гемофилии, при браке со здоровым мужчиной, будут рождаться здоровые девочки, половина из которых являются носителями гена гемофилии, и половина здоровых мальчико и другая половина больных мальчиков. Вероятность рождения девочек-носительниц данной мутации составляет 25% и вероятность мальчиков-гемофиликов составляет тоже 25%.
Таким образом, у женщины носительницы гена гемофилии, при браке с здоровым мужчиной возможно рождение мальчиков-гемофиликов составляет 25%, а все девочки рождаются здоровыми, половина из которых будут являться носителями гена гемофилии.
1 Серповидноклеточная анемия (изменение в молекулярной структуре гемоглобина, приводящее к потере способности транспорта кислорода и серповидной форме эритроцитов) наследуется как неполностью доминантный признак: у гомозигот развивается сильная анемия, заканчивающаяся обычно смертельным исходом; гетерозиготы имеют легкую форму анемии. Ген серповидноклеточной анемии одновременно обусловливает невосприимчивость к малярии и наследуется независимо от гена, определяющего группу крови по системе АВО.
Генетика серповидноклеточной анемии. Наследование
Генетика серповидноклеточной анемии. Наследование
HbS был первым обнаруженным аномальным гемоглобином с высоким клиническим значением. Он возникает вследствие замены единственного нуклеотида, которая изменяет кодон шестой аминокислоты В-глобина глутаминовой кислоты на валин (GAG -> GTG: Glu6Val).
Гомозиготность по данной мутации — причина серповидноклеточной анемии, серьезного заболевания, часто встречающегося в некоторых частях света. Болезнь имеет характерное географическое распределение, чаще всего встречается в Экваториальной Африке и реже всего в Средиземноморье, Индии и странах, в которые мигрировали люди из этих регионов. С этой, обычно фатальной в раннем детстве болезнью рождаются около 1 из 600 афроамериканцев, хотя все более частым становится более долгое выживание.
Серповидноклеточная анемия — тяжелое аутосомно-рецессивное гемолитическое заболевание, характеризующееся тенденцией эритроцитов принимать выраженно аномальную форму (серпа) в условиях низкого насыщения кислородом. Гетерозиготы, про которых говорят, что они имеют «признак» серповидноклеточно-сти, обычно клинически здоровы, но их эритроциты в условиях очень низкого давления кислорода in vitro принимают форму серпа.
Случаи, когда бы это могло происходить in vivo, редки, хотя гетерозиготы имеют риск инфаркта селезенки, особенно при полетах на большой высоте в самолетах с низким давлением в кабине. Гетерозиготное состояние наблюдают приблизительно у 8% афроамериканцев, но в областях, где частота гена высокая (например, в Западной Центральной Африке), вплоть до 25% новорожденных — гетерозиготы.
Молекулярная патология HbS - серповидноклеточной анемии
Около 50 лет тому назад Ингрэм обнаружил, что аномалия HbS связана с заменой одной из 146 аминокислот в В-цепи молекулы гемоглобина. Все клинические проявления наличия HbS — последствия этого единственного изменения в гене В-глобина. Это было первой демонстрацией того, что мутация в структурном гене может вызывать замену аминокислоты в соответствующем белке. Поскольку аномалия HbS локализуется в В-цепи, формула HbS может быть записана как а2b2s или, более точно, а2Ab2s.
Гетерозиготы имеют смесь двух типов гемоглобинов (НbА и HbS), обозначаемых а2Аb2А, а2Аbs, а также гибридный тетрамер гемоглобина, обозначаемый как a2AbA,bs.
Серповидноклеточность и ее последствия
Молекулы гемоглобина, содержащие мутантные субъединицы b-глобина, нормальны по их способности выполнять их главную функцию связывания кислорода (если они не полимеризованы, как указано далее), но в ненасыщенной кислородом крови они растворимы в пять раз меньше по сравнению с нормальным гемоглобином. Относительная нерастворимость дезоксигемоглобина S является физической основой феномена серповидноклеточности.
В условиях низкой кислородной напряженности молекулы HbS собираются в форме полимеров, формирующих стержни или волокна, искажающие форму эритроцитов. Эти уродливые эритроциты деформируются хуже, чем в норме, и, в отличие от нормальных красных кровяных клеток, не могут сжиматься, проходя через капилляры, тем самым блокируя ток крови и вызывая локальную ишемию.
Происхождение мутаций гемоглобина S
У большинства лиц африканского происхождения нормальный ген b-глобина содержится в пределах фрагмента рестрикции размером в 7,6 килобазы ДНК. В то же время в определенных частях Африки, например в Гане и почти у 70% афроамериканцев, аллель серповидноклеточного глобина часто обнаруживают во фрагменте размером в 13 килобаз. Частая ассоциация серповидноклеточного глобина с 13-килобазовым фрагментом — поразительный пример неравновесного сцепления.
В других частях Африки (например, в Кении) мутация серповидноклеточности обычно связана с фрагментом размером в 7,6 килобазы. Эти находки позволяют утверждать, что мутация серповидноклеточности возникла в Западной Африке в хромосоме, которая содержала ген р-глобина во фрагменте длиной 13 килобаз, и что подобная мутация, по крайней мере, один раз, независимо произошла где-то еще. Защита от малярии, обеспечиваемая данной мутацией у гетерозигот, обеспечила ее высокую частоту в областях, пораженных малярией.
Редактор: Искандер Милевски. Дата обновления публикации: 18.3.2021
Анемия серповидноклеточная
Подробнее о составе и биологической роли крови, о сути анемий – см. материал «Анемия. Кровь и бескровие».
Можно предполагать, что генетическая мутация, приводящая к серповидноклеточной анемии, появилась на Африканском континенте – и закрепилась в популяции, как ни странно, в качестве полезного признака: носители гена и больные этой формой анемии обнаруживают относительную устойчивость к малярии. Малярийный плазмодий паразитирует на красных кровяных тельцах и разрушает их, однако эритроциты, генетически изувеченные и несущие совсем другой гемоглобин (см.ниже), для плазмодия «несъедобны». И хотя анемия малярии не слаще, но летальность болотной лихорадки все-таки выше: выживали те, у кого был хоть какой-то иммунитет.
В активно мигрирующем человечестве, которое становится все более интернациональным и постепенно интеррасовым, серповидноклеточная анемия распространена повсеместно. Впрочем, определенная эндемичность сохраняется и сегодня: в Экваториальной Африке, Средиземноморском бассейне, Индии, на Ближнем Востоке частота генетического носительства (не путать с заболеваемостью в клинической форме) достигает 40%.
Согласно специальному исследованию, проведенному в 2001 году на Ямайке, средняя продолжительность жизни больных с гомозиготной серповидноклеточной анемией составляет 53 года для мужчин и 58 лет для женщин. До 20 лет доживают около 90%, до 50 лет – примерно половина.
Иными словами, проблема является весьма серьезной, она характеризуется высокой медико-социальной значимостью и нуждается в эффективных решениях, – поиск которых в настоящее время ведется ведущими специализированными научно-исследовательскими центрами. Распространенность наследственных гемоглобинопатий (включая серповидноклеточную анемию) в мире оценивается на уровне 3-7%. В начале 2010-х годов ВОЗ отнесла серповидноклеточную анемию к глобальным проблемам здравоохранения.
Эпидемиологическая ситуация и показатели летальности в странах третьего мира неизвестны или недостаточно достоверны.
Согласно литературным данным, вследствие миграционных процессов заболеваемость в России обнаруживает значимую и устойчивую тенденцию к возрастанию, особенно в Москве и Санкт-Петербурге.
Причины
S-гемоглобин (от англ. «a sickle» – серп), кодируемый сбойным геном, является значительно более вязким и примерно в сто раз хуже растворяется, чем нормальный А-гемоглобин; кроме того, многократно ниже способность связывать кислород и транспортировать его к тканям, – чем и вызывается собственно анемическая симптоматика гипоксии. Эритроциты, содержащие измененный гемоглобин, формой вытянутого деформированного полумесяца или серпа отличаются от нормальных кровяных телец, имеющих вид сравнительно толстого двояковогнутого диска. Неестественная форма и жесткость S-эритроцитов обусловливает тенденцию к закупорке ими капиллярных русел. Гемолиз резко ускорен, т.е. срок жизни S‑эритроцитов по сравнению с нормальными красными клетками гораздо короче.
В крови больного могут присутствовать как нормальные, так и аномальные эритроциты, либо же только аномальные. Очевидно, что во втором случае заболевание протекает намного тяжелее и прогноз хуже; первый же вариант может быть мало- или даже бессимптомным.
Тип наследования – аутосомно-рецессивный. Это означает, что у двух родителей – носителей гена вероятность рождения ребенка с этим же геном составляет 50%, а с клинической формой серповидноклеточной анемии – 25%. Если носителем является лишь один из родителей, вероятность наследования гена остается пятидесятипроцентной, но само заболевание у ребенка не манифестирует.
Симптоматика
Как и большинство генетических заболеваний, серповидноклеточная анемия характеризуется чрезвычайным разнообразием возможных симптомов, синдромов и осложнений. Вариативность их настолько велика, что никакую клиническую картину и никакой индивидуальный случай нельзя считать типичными.
Дебют в большинстве случаев приходится на раннее детство, и затем в развитии заболевания прослеживаются три периода.
В начальном периоде, как правило, доминирует симптоматика микротромбоза, костно-суставные боли и боли другой локализации, опухлость суставов, увеличение селезенки, желтушность (обусловленная ускоренным распадом гемоглобина). Такие дети весьма предрасположены к инфекциям, в том числе к остеомиелитам. Течение болезни на этом этапе зачастую носит кризовый характер и легко усугубляется при любых неблагоприятных условиях. Например, криз гемолитического типа нередко провоцируется инфекцией и может результировать фатально; апластический, секвестрационный, сосудистый (тромботический) кризы также представляют собой жизнеугрожающие синдромы.
Во многих случаях имеет место характерная деформация структур опорно-двигательного аппарата и костей черепа: кифоз, лордоз, акроцефалия («башенный череп»), а также серьезные задержки психофизического развития.
На втором этапе может наблюдаться аномально интенсивная продукция эритроцитов как компенсация их несостоятельности. В силу тромбоза нередко развивается сердечная или почечная недостаточность, инсульты, сахарный диабет, цирроз печени, трофические язвы ног. Большинство больных со столь тяжелой картиной второго периода погибает в течение нескольких лет.
Третий период, если он вообще наступает, характеризуется умеренной гемолитической симптоматикой. Отсутствие селезенки (см. выше) обусловлено феноменом сморщивания и самоуничтожения (аутоспленэктомия) после повторных ее инфарктов. Печень остается увеличенной, высока предрасположенность к гнойно-воспалительному течению любых инфекционных заболеваний.
Факультативными (возможными в разных случаях, но не обязательными) осложнениями серповидноклеточной анемии выступают желчнокаменная болезнь, асептический некроз костных тканей (аваскулярный остеонекроз), иммунодефицит, приапизм у мужчин, преэклампсия и выкидыши у беременных женщин, задержки внутриутробного развития плода, острый ренальный некроз, ретинопатия (отслоение сетчатки может результировать полной слепотой), легочная гипертензия и мн.др.
Характерны более или менее продолжительные приступы острой боли в костях, суставах и мышцах. Национальная служба здравоохранения Великобритании включила серповидноклеточную анемию в список наиболее болезненных состояний .
Диагностика
Диагноз устанавливается по характерному сочетанию общей для анемий симптоматики и специфических проявлений. Производится тщательное многофакторное лабораторное исследование крови. Назначается медико-генетическое обследование.
Лечение
На сегодняшний день существует лишь паллиативное, симптоматическое лечение, что во многих случаях требует участия нескольких профильных специалистов. Большое значение имеет профилактика инфекционных заболеваний, полноценное питание, контроль достаточного потребления витаминов (особенно В9 и В12).
Следует отметить, что в марте 2017 года «The New England Journal of Medicine» опубликовал статью, где большим коллективом авторов сообщалось о первом в истории случае существенного облегчения серповидноклеточной анемии методом генной инженерии. Французский подросток получил такое лечение в университетской клинике Некёр (Париж), известной с 1802 года как первое в мире специализированное медучреждение для детей.
Однако прогноз дальнейшего развития и течения болезни, равно как и перспективы внедрения метода в клиническую практику, пока неясны. Хотелось бы надеяться, что этот успех, – безусловно, выдающийся! – ознаменует долгожданную и столь необходимую революцию в лечении серповидноклеточной анемии и, вообще, хромосомных болезней.
Серповидно-клеточная анемия ( S-гемоглобинопатия )
Серповидно-клеточная анемия – наследственная гемоглобинопатия, обусловленная синтезом аномального гемоглобина S, изменением формы и свойств эритроцитов крови. Серповидно-клеточная анемия проявляется гемолитическими, апластическими, секвестрационными кризами, тромбозами сосудов, костно-суставными болями и припухлостью конечностей, изменениями скелета, сплено- и гепатомегалией. Диагноз подтверждается по данным исследования периферической крови и пунктата костного мозга. Лечение серповидно-клеточной анемии является симптоматическим, направленным на предупреждение и купирование кризов; может быть показано переливание эритроцитов, прием антикоагулянтов, проведение спленэктомии.



Общие сведения
Серповидно-клеточная анемия (S-гемоглобинопатия) – разновидность наследственной гемолитической анемии, характеризующаяся нарушением структуры гемоглобина и присутствием в крови эритроцитов серповидной формы. Заболеваемость серповидно-клеточной анемией распространена, главным образом, в странах Африки, Ближнего и Среднего Востока, Средиземноморского бассейна, Индии. Здесь частота носительства гемоглобина S среди коренного населения может достигать 40%. Любопытно, что больные серповидно-клеточной анемией имеют повышенную врожденную устойчивость к заражению малярией, поскольку малярийный плазмодий не может проникнуть в эритроциты серповидной формы.

Причины
В основе серповидно-клеточной анемии лежит генная мутация, обусловливающая синтез аномального гемоглобина S (HbS). Дефект структуры гемоглобина характеризуется заменой глутаминовой кислоты валином в ß-полипептидной цепи. Образующийся при этом гемоглобин S после потери присоединенного кислорода приобретает консистенцию высокополимерного геля и становится в 100 раз менее растворимым, чем нормальный гемоглобин А. В результате этого эритроциты, несущие деоксигемоглобин S, деформируются и приобретают характерную полулунную (серповидную) форму. Измененные эритроциты становятся ригидными, малопластичными, могут закупоривать капилляры, вызывая ишемию тканей, легко подвергаются аутогемолизу.
Наследование серповидно-клеточной анемии происходит по аутосомно-рецессивному типу. При этом, гетерозиготы наследуют дефектный ген серповидно-клеточной анемии от одного из родителей, поэтому, наряду с измененными эритроцитами и HbS, имеют в крови и нормальные эритроциты с HbА. У гетерозиготных носителей гена серповидно-клеточной анемии признаки заболевания возникают лишь в определенных условиях. Гомозиготы наследуют по одному дефектному гену от матери и от отца, поэтому в их крови присутствуют только серповидные эритроциты с гемоглобином S; заболевание развивается рано и протекает тяжело.
Таким образом, в зависимости от генотипа, в гематологии различают гетерозиготную (HbAS) и гомозиготную (HbSS, дрепаноцитоз) форму серповидно-клеточной анемии. К редко встречающимся вариантам заболевания относятся промежуточные формы серповидно-клеточной анемии. Обычно они развиваются у двойных гетерозигот, несущих один ген серповидно-клеточной анемии и другой дефектный ген - гемоглобина C (HbSC), серповидной β-плюс (HbS/β +) или β-0 (HbS/β0) талассемии.
Симптомы серповидно-клеточной анемии
Гомозиготная серповидно-клеточная анемия обычно проявляется у детей к 4-5 месяцу жизни, когда увеличивается количество HbS, а процентное содержание серповидных эритроцитов достигает 90%. В таких случаях раннее возникновение гемолитической анемии у ребенка обуславливает задержку физического и умственного развития. Характерны нарушения развития скелета: башенный череп, утолщение лобных швов черепа в виде гребня, кифоз грудного или лордоз поясничного отдела позвоночника.
В развитии серповидно-клеточной анемии выделяют три периода: I - с 6 месяцев до 2-3 лет, II - с 3 до 10 лет, III - старше 10 лет. Ранними сигналами серповидно-клеточной анемии служат артралгии, симметричное опухание суставов конечностей, боли в груди, животе и спине, желтушность кожи, спленомегалия. Дети с серповидно-клеточной анемией относятся к категории часто болеющих. Степень тяжести течения серповидно-клеточной анемии тесно коррелирует с концентрацией HbS в эритроцитах: чем она выше, тем тяжелее выражена симптоматика.
В условиях интеркуррентной инфекции, стрессовых факторов, обезвоживания, гипоксии, беременности и пр. у больных данным видом наследственной анемии могут развиваться серповидно-клеточные кризы: гемолитический, апластический, сосудисто-окклюзионный, секвестрационный и др.
При развитии гемолитического криза состояние больного резко ухудшается: возникает фебрильная лихорадка, в крови повышается непрямой билирубин, усиливается желтушность и бледность кожных покровов, появляется гематурия. Стремительный распад эритроцитов может привести к анемической коме. Апластические кризы при серповидно-клеточной анемии характеризуются угнетением эритроидного ростка костного мозга, ретикулоцитопенией, снижением гемоглобина.
Следствием депонированием крови в селезенке и печени служат секвестрационные кризы. Они сопровождаются гепато- и спленомегалией, сильными болями в животе, резкой артериальной гипотонией. Сосудисто-окклюзионные кризы протекают с развитием тромбоза сосудов почек, ишемии миокарда, инфаркта селезенки и легких, ишемического приапизма, окклюзии вен сетчатки, тромбоза мезентериальных сосудов и др.
Гетерозиготные носители гена серповидно-клеточной анемии в обычных условиях ощущают себя практически здоровыми. Морфологически измененные эритроциты и анемия у них возникают только в ситуациях, связанных с гипоксией (при тяжелой физической нагрузке, авиаперелетах, восхождении в горы и др.). Вместе с тем, остро развившийся гемолитический криз при гетерозиготной форме серповидно-клеточной анемии может иметь летальный исход.

Осложнения
Хроническое течение серповидно-клеточной анемии с повторными кризами приводит к развитию целого ряда необратимых изменений, нередко становящихся причиной гибели больных. Примерно у трети больных отмечается аутоспленэктомия – сморщивание и уменьшение размеров селезенки, вызванное замещением функциональной ткани рубцовой. Это сопровождается изменением иммунного статуса больных серповидно-клеточной анемией, более частым возникновением инфекций (пневмонии, менингита, сепсиса и др.).
Исходом сосудисто-окклюзионных кризов могут стать ишемические инсульты у детей, субарахноидальные кровоизлияния у взрослых, легочная гипертензия, ретинопатия, импотенция, почечная недостаточность. У женщин с серповидно-клеточной анемией отмечается позднее становление менструального цикла, склонность к самопроизвольному прерыванию беременности и преждевременным родам. Следствием ишемии миокарда и гемосидероза сердца служит возникновение хронической сердечной недостаточности; повреждения почек - хронической почечной недостаточности.
Длительный гемолиз, сопровождаемый избыточным образованием билирубина, приводит к развитию холецистита и желчнокаменной болезни. У больных серповидно-клеточной анемией часто возникают асептические некрозы костей, остеомиелит, язвы голеней.
Диагностика
Диагноз серповидно-клеточной анемии выставляется гематологом на основании характерных клинических симптомов, гематологических изменений, семейно-генетического исследования. Факт наследования ребенком серповидно-клеточной анемии может быть подтвержден еще на этапе беременности с помощью биопсии ворсин хориона или амниоцентеза.
В периферической крови отмечается нормохромная анемия (1-2х1012/л), снижение гемоглобина (50-80 г/л), ретикулоцитоз (до 30%). В мазке крови обнаруживаются серповидно измененные эритроциты, клетки с тельцами Жолли и кольцами Кабо. Электрофорез гемоглобина позволяет определить форму серповидно-клеточной анемии – гомо- или гетерозиготную. Изменение биохимических проб крови включает гипербилирубинемию, увеличение содержания сывороточного железа. При исследовании пунктата костного мозга выявляется расширение эритробластического ростка кроветворения.
Дифференциальная диагностика направлена на исключение других гемолитических анемий, вирусного гепатита А, рахита, ревматоидного артрита, туберкулеза костей и суставов, остеомиелита и др.

Лечение серповидно–клеточной анемии
Серповидно-клеточная анемия относится к категории неизлечимых болезней крови. Таким пациентам требуется пожизненное наблюдение гематолога, проведение мероприятий, направленных на предупреждение кризов, а при их развитии – проведение симптоматической терапии.
В период развития серповидно-клеточного криза требуется госпитализация. С целью быстрого купирования острого состояния назначается кислородотерапия, инфузионная дегидратация, введение антибиотиков, обезболивающих средств, антикоагулянтов и дезагрегантов, фолиевой кислоты. При тяжелом течении обострений показано переливание эритроцитарной массы. Проведение спленэктомии не способно повлиять на течение серповидно-клеточной анемии, однако может на время уменьшить проявления заболевания.
Прогноз и профилактика
Прогноз гомозиготной формы серповидно-клеточной анемии неблагоприятный; большая часть пациентов погибает в первое десятилетие жизни от инфекционных или тромбоокклюзионных осложнений. Течение гетерозиготных форм патологии гораздо более обнадеживающее.
Для предупреждения быстро прогрессирующего течения серповидно-клеточной анемии следует избегать провоцирующих условий (обезвоживания, инфекций, перенапряжения и стрессов, экстремальных температур, гипоксии и пр.). Детям, страдающим данной формой гемолитической анемии, в обязательном порядке показана вакцинация против пневмококковой и менингококковой инфекции. При наличии в семье больных серповидно-клеточной анемией необходима медико-генетическая консультация для оценки риска развития заболевания у потомства.
Читайте также:
